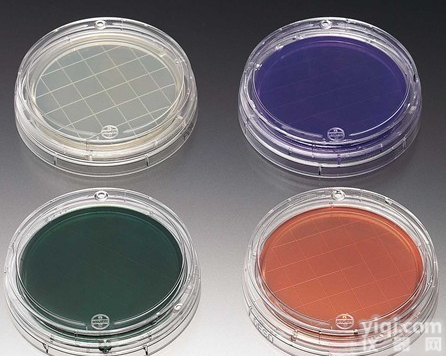
茜素-β-半<em>乳糖</em>苷<em>肉汤</em>（Aliz-gal<em>肉汤</em>）

煌绿乳糖胆盐肉汤(BGLB)现货供应
- 产地:中国大陆
- 供应商:上海邦景实业有限公司
- 供应商报价:电议
- 标签:煌绿乳糖胆盐肉汤(BGLB)现货供应,生物试剂,生化试剂,供应煌绿乳糖胆盐肉汤(BGLB)现货供应,上海邦景实业有限公司
煌绿乳糖胆盐肉汤(BGLB)"贮存:培养基在30℃下放置一天,无污染的即可使用。一般用牛皮纸包裹好存放于2-8℃冰箱中备用。
"规格:250g用途:用于大肠菌群、大肠杆菌的测定(GB、SN标准)
产品名称: 煌绿乳糖胆盐肉汤(BGLB)
规格:250g/瓶
作用:用于肠道致病菌的增菌(日本)
使用范围:仅供科研使用
库存:提供现货(因销量问题库存会有变动,具体请与销售人员确认)
保存:低温避光保存
| 产品名称 | 煌绿乳糖胆盐肉汤(BGLB) |
| 货期 | 3-5天 |
| 价格 | 来电可享受优惠 |
实验内容 :
1.称量→溶化→调pH→过滤→分装→加塞→包扎→灭菌→无菌检查
2.干热灭菌:装入待灭菌物品→升温→恒温→降温→开箱取物
3.高压蒸汽灭菌:加水→装物品→加盖→加热→排冷空气→加压→恒压→降压回零→排汽→取物→无菌检查
4.过滤CJ:组装灭菌→连接→压滤→无菌检查→清洗灭菌
贮存方法:培养基由于配制的原料不同,使用要求不同,而贮存保管方面也稍有不同。一般培养基在受热、吸潮后,易被细菌污染或分解变质,因此一般培养基必须防潮、避光、阴凉处保存。对一些需严格灭菌的培养基(如组织培养基),较长时间的贮存,必须放在2~6℃的冰箱内。由于液体培养基不易长期保管,现在均改制成粉末。
我们拥有经验丰富的化学师严格为质量把关。我们的技术服务人员随时为您解答有关产品的任何问题。
KCTD12?0.1ml
抑癌蛋白EZH2抗体英文名称:KMT6?0.2ml
DNA修复酶Ku70抗体英文名称:Ku-70?0.1ml
DNA修复酶Ku-80抗体英文名称:Ku-80?0.1ml
14号染色体开放阅读框106抗体英文名称:C14orf106?0.2ml
脑蛋白9抗体英文名称:KNDC1?0.2ml
钾通道相互作用蛋白2抗体英文名称:KChIP2?0.2ml
剑蛋白p60亚基A1抗体英文名称:Katanin p60 A1?0.2ml
Kazrin蛋白抗体英文名称:Kazrin?0.2ml
钾离子通道多聚体结构域蛋白8抗体英文名称:KCTD8?0.2ml
磷酸化Ras信号转导KSR1蛋白抗体英文名称:Phospho-KSR1 (Ser392)?0.1ml
抗体英文名称:Ketamine(4E2)?0.1ml
激肽释放酶7抗体英文名称:KLK7?0.2ml
激肽释放酶9抗体(舒血管素9)英文名称:KLK9?0.1ml
激肽释放酶14抗体英文名称:KLK14?0.2ml
钾电压阀门通道混合器相关亚家族成员7抗体英文名称:KCNA7?0.1ml
ATP敏感性钾通道亚基kir6.2抗体英文名称:Kir6.2?0.1ml
TIP60抗体英文名称:KAT5?0.1ml
组蛋白赖氨酸特异性脱甲基酶1抗体英文名称:KDM1?0.1ml
转录因子GATA3结合蛋白G3B抗体英文名称:KMT8?0.2ml
磷酸化周期蛋白依赖激酶YZ因子1C抗体英文名称:Phospho-p57 Kip2 (Thr310)?0.1ml
磷酸通道蛋白DRK1抗体英文名称:phospho-Kv2.1(Tyr128)?0.1ml
离子通道蛋白Kv3.4抗体英文名称:KCNC4?0.2ml
离子通道蛋白Kv3.3抗体英文名称:KCNC3/Kv3.3?0.1ml
组蛋白去甲基化酶JMJD2B抗体英文名称:KDM4B?0.2ml
肝果糖激酶抗体英文名称:Ketohexokinase?0.1ml
脊柱侧后凸畸形肽酶抗体英文名称:KY?0.2ml
组蛋白乙酰转移酶PCAF抗体英文名称:KAT2B?0.1ml
磷酸化原癌基因c-kit抗体英文名称:Phospho-c-Kit(Ser741)?0.1ml
煌绿乳糖胆盐肉汤(BGLB)磷酸化原癌基因c-kit抗体英文名称:Phospho-c-Kit(Ser721)?0.1ml
离子通道蛋白Kv3.1抗体英文名称:KCNC1?0.1ml
激肽释放酶11抗体英文名称:KLK11?0.1ml
k轻链抗体英文名称:Kappa Light Chain?0.1ml
丝氨酸/苏氨酸蛋白激酶KIST抗体(激酶相互作用与白血病相关基因)英文名称:KIST?0.2ml